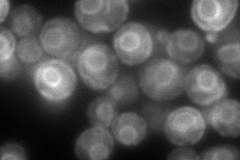
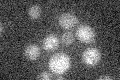

View description
Spore-specific water channel that mediates the transport of water across cell membranes, developmentally controlled; may play a role in spore maturation, probably by allowing water outflow, may be involved in freeze tolerance
Localization:
Intensity:
Fold change:
Significance:
-
C’ GFP library in SD

below threshold13.98 -
N' NOP1pr-GFP in SD

ER212.156 -
N' TEF2pr-mCherry in SD
ER144.372 -
N' NATIVEpr-GFP in SD

below threshold19.0691 -
N' TEF2pr-VC and Cyto-VN in SD

ER49.1286 -
C’ GFP library in SD+DTT

cytosol14.631.04No -
C’ GFP library in SD+H2O2

cytosol13.270.94No -
C’ GFP library in Starvation Media
cytosol14.41.02No -
C’ GFP library on the background of Pup2-DaMP

below threshold -
C’ GFP library on the background of CCT mutant

below threshold13.71220.979735No
